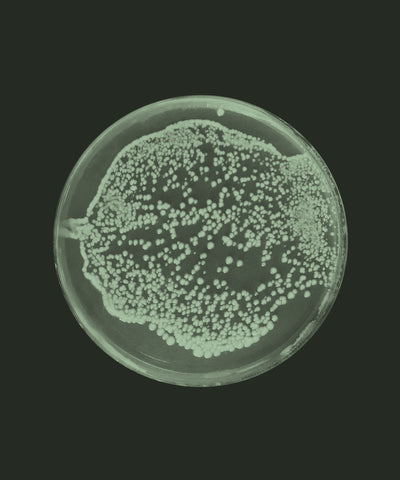
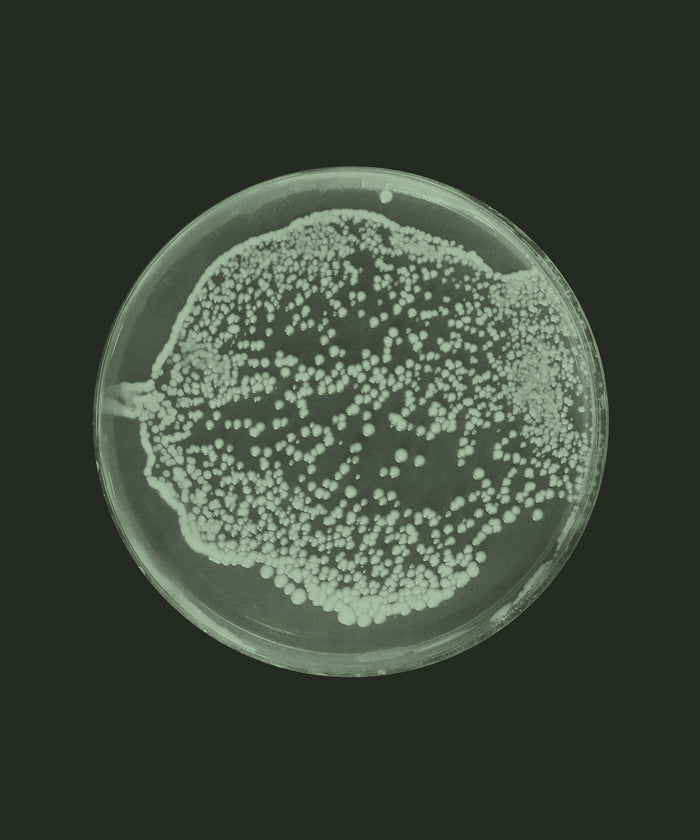
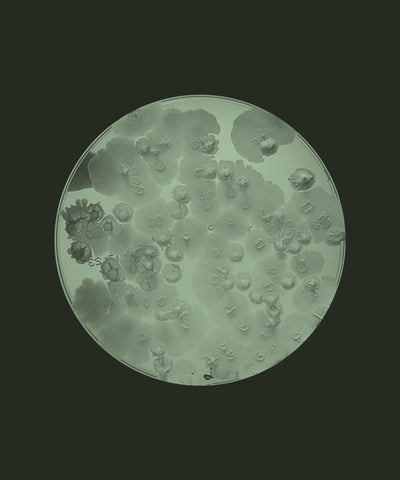

WE FORMULATE WITH INGREDIENTS THAT HAVE BEEN METICULOUSLY SOURCED, SURPASSING OUR STANDARDS OF SIMPLICITY, PURITY AND EFFICACY

proprietary ingredient
proprietary ingredient




























 proprietary ingredient
proprietary ingredient